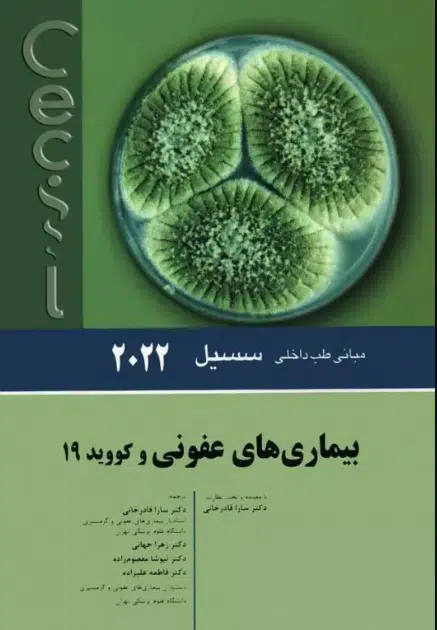
98 کتاب مبانی طب داخلی سسیل 2022 بیماریهای عفونی و کووید 19

-
نویسندگان:ادوارد جی وینگ , فرد جی شیفمنمترجمان:
-
ناشراندیشه رفیع
-
شابک9786222730864
-
سال چاپ 1402
-
قطع وزیری
-
نوع جلدشومیز (جلد نرم)
-
تعداد صفحات248
-
وزن400 گرم
کتاب مبانی طب داخلی سسیل 2022 بیماریهای عفونی و کووید 19
290.000 تومان قیمت اصلی: 290.000 تومان بود.237.800 تومانقیمت فعلی: 237.800 تومان.

دیدگاهها
هیچ دیدگاهی برای این محصول نوشته نشده است.